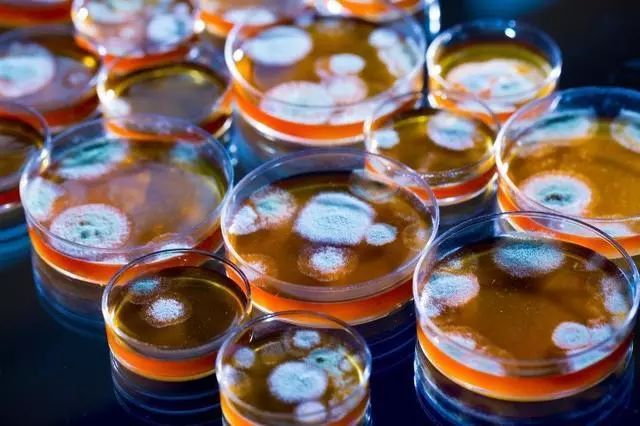

欧美医院没有青霉素皮试,他们不怕过敏吗?
每次去医院打青霉素前,护士都要先拿一个小针管,在我们的手腕上做一个小小的测试——皮试,这个操作是用来判断你会不会出现青霉素过敏的症状。一旦发生青霉素过敏,轻则肺部水肿呼吸困难,重则过敏性休克。

青霉素皮试
如果把注射青霉素制剂比作结婚,那皮试就如同婚姻大事前的相亲。相亲通过了,才有继续交往的可能;如果不通过,那就要第一时间打断,最大可能地提高效率,并阻止伤害。
然而,皮试在中国和欧美国家的境遇是冰火两重天——国内要求必须进行皮试,欧美国家却不需要。这背后的原因究竟是什么呢?
太长不看版:
1)青霉素过敏主要是由于青霉素制剂里的杂质;
2)皮试能有效降低患者发生过敏性休克等风险,但很多因素可能会导致皮试出现伪结论;
3)青霉素提纯环节的工艺是国内的技术短板,衡量生产成本和使用量之后,严谨的皮试更加划算;
4)欧美国家更注重青霉素过敏的既往史,对注射过程把控严格;而在医疗资源和医患关系都相对紧张的国内,规范的皮试更为可行。
为什么会青霉素过敏?
这首先得说说,为什么会有青霉素过敏。青霉素过敏真正的元凶并不是青霉素君本尊,它只是替别人背了口锅而已……真正的始作俑者,主要是青霉素制剂中的杂质。
青霉素分子本身不能直接引发过敏反应,但青霉素的分子结构非常不稳定,它在生产过程及之后的储存过程中,容易发生分解,产生青霉噻唑(青霉素杂质的一种)。青霉噻唑分子进入人体后,与体内的蛋白质结合,会生成青霉噻唑蛋白。这是一种杀伤力很强的蛋白质,正是它,造成了绝大多数人的过敏反应。
培养皿中的青霉素
于是,为了尽可能避免注射青霉素制剂造成的过敏反应,国内要求在注射青霉素前,一定要先进行审核,也就是皮试。
那么,问题来了。通过了皮试,就一定不会发生过敏现象了吗? 就如同经过了理智相亲再开始的恋爱和婚姻,就一定能幸福美满吗?
答案是——不。
皮试结论一定准吗?
皮试是出于安全目的而对患者进行的一种风险预测手段,目的是降低青霉素过敏的发生概率——也就是说,允许我们在相亲的时候就将渣男拒之门外。
研究表明,科学、规范的青霉素皮试对成人、儿童过敏性休克等有良好的预测作用,其阴性预测值可达97%~99%,也就是说皮试阴性的患者有1%~3%的可能发生过敏反应。总体看来,皮试可有效降低患者发生过敏性休克等的风险,这是皮试的功劳。

青霉素过敏导致的皮疹
但皮试做为一种筛查手段,本身就存在着无法避免的问题——假阴性和假阳性。
假阴性:明明是渣男,错看成暖男——嫁错人,悔终身。
假阳性:明明是暖男,却误以为渣——错过你,就错过了全世界。
为什么皮试时而靠谱又时而不靠谱呢?实在是因为,人的体质千千万万,不良反应如万花筒,很多因素都有可能导致伪结论的出现。比如,如果患者正在服用治疗鼻炎的氯雷他定,在青霉素皮试中就可能出现假阴性结果;而肤质过于敏感的患者,在皮试后又有可能出现假阳性。
当然,让情况变得更复杂的还有:药物在特殊理化环境中的各种变化、医护人员操作的不规范、对结果的判断不统一……这些因素都有可能对皮试结果造成干扰。
为什么国内外对皮试有不同的态度?
正因为皮试的结果并不一定精准,只能作为参考,于是中国和欧美国家对于皮试拿出了不同的态度。

中国目前规定,在使用青霉素类药物前,必须先对所有患者进行常规皮试。
与此同时,欧美国家指南规定:在青霉素肌注或静脉注射前不需要常规行青霉素皮肤试验,而怀疑有青霉素过敏史的患者,会由过敏科医师进行一系列检查。
而在不同态度的背后,还有着这些更深的原因。
1
青霉素纯度有别
鉴于导致过敏的主要是青霉素以外的杂质,因此杂质浓度的高低往往决定了青霉素过敏发生概率的高低。因此,要想达到“免(皮)试”的水平,青霉素的浓度是最关键的指标。
青霉素的生产过程是先合成后提纯,即先生产出青霉素,再去除杂质。这是因为青霉素分子结构不稳定,在合成的过程中就会分解出不少杂质。于是,青霉素纯度的高低主要取决于青霉素生产过程中的提纯环节,而这一环节所需的工艺恰恰是国内的技术短板,所以国内青霉素制剂中杂质的浓度就相对较高,之后发生青霉素过敏的概率也就相对更高。

国产青霉素注射液
如果要加强工艺,降低杂质的浓度,那么一个最直接的结果就是——青霉素的生产成本提高。据统计,国内通用的青霉素,价格在6~7元人民币一支,而欧美市场的青霉素,价格相当于30~40元人民币一支。如果国内想生产出与欧美杂质含量相当的青霉素,由于技术引进等一系列原因,青霉素的价格可能会上升到60~70元人民币每支,那么青霉素物美价廉的药品地位就会被直接动摇。
青霉素的使用量这么大,既然纯度差了些,那使用国产青霉素前进行严谨的皮试就好了,以尽可能排除青霉噻唑蛋白过敏的可能。国产青霉素的价格优势也使得这种策略的可行性大大增加。

欧美市场的青霉素 | healthcrafter.net
而欧美国家生产青霉素的工艺水平已足以生产出杂质浓度很低的青霉素,使得青霉素过敏的发生率只有0.004%-0.015%。这个时候,再挨个儿给每一个患者做皮试,反而很不划算。所以,欧美国家对青霉素采用“免(皮)试”策略。
2
综合考虑后当下的最好选择
欧美国家更注重患者是否有青霉素过敏的既往史,并且对整个注射过程进行严加把控。
在美国,如果患者需要注射青霉素,医生会仔细询问患者的既往史,如果既往出现过喉头水肿或者过敏性休克等严重副作用,则禁止再使用青霉素。并且,首次注射必须由医生执行,一般选择逐级剂量注射(graded-dose),首次剂量通常是标准剂量的1/100;如果30分钟之后患者反应良好,则选择全剂量注射。后续的注射和观察则由护士进行,治疗室里同时准备好充足的地塞米松和肾上腺素等急救药物及设备以应对紧急情况。也就是说,即使患者发生了青霉素过敏,也有完善的后续抢救机制和抢救药品的供应。

药物筛查表 | Pixabay
中国难以忽视医疗资源有限甚至是缺乏、医患关系也相对更紧张的现实条件。假设我们和欧美国家面临的青霉素过敏风险系数一致(实际上国内生产的青霉素大多纯度偏低,风险系数会更大),由于国内人口基数大、患者基数相对多,那么总风险也就相对更大。如果发生青霉素过敏反应,需要消耗的医疗资源和人力资源势必也就更多。所以,综合考虑后,注射青霉素前进行规范的皮试操作无疑是最简单经济且符合国情的方式。

图 | Pixabay
只能说,大怪兽小怪兽都是怪兽,无论选择怎样的打法,只要能因地制宜、最大化地保障各国患者和青霉素君完美结合,就是最好。
作者:安汀
编辑:黎小球
一个AI
AI隔壁的人类,听到青霉素竟然想到了冻干草莓?怎么肥事?
噢,原因是这个:别人用它提纯青霉素、造血浆,意大利人用它来做意大利面?真的假的?
本文来自果壳,谢绝转载.如有需要请联系sns@guokr.com
(欢迎转发到朋友圈~)
果壳
ID:Guokr42
整天不知道在科普啥的果壳
建议你关注一下





